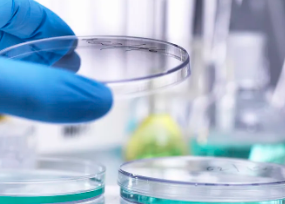
image.png

新基态幹細胞移植費用是多少,其治療效果如何保障
2024-12-06 15:42:09 來源: 小編 咨詢醫生
幹細胞移植技術在近年來取得了顯著的進展,尤其是新基态幹細胞移植,爲許多疾病的治療帶來了新的希望。本文将圍繞“新基态幹細胞移植費用及其治療效果保障”的話題,爲您詳細解析這一技術。
一、新基态幹細胞移植費用
新基态幹細胞移植的費用因地域、醫院、病情等因素而異。在我國,新基态幹細胞移植的費用一般在10萬元至30萬元人民币之間。具體費用需根據患者的實際情況和醫院的收費标準來确定。需要注意的是,費用并非唯一考量因素,患者在選擇醫院和醫生時,更應關注其技術水平和臨床經驗。
二、新基态幹細胞移植治療效果
1.治療範圍廣泛
新基态幹細胞移植技術可應用于多種疾病的治療,如血液病、神經系統疾病、免疫系統疾病等。該技術具有修複受損組織、促進細胞再生、提高免疫力等多種作用,爲患者帶來了新的治療選擇。
2.安全性高
新基态幹細胞移植采用自體或同種異體幹細胞,避免了免疫排斥和病毒感染的風險。同時,該技術具有較高的純淨度,降低了并發症的發生率。
3.治療效果顯著
新基态幹細胞移植在臨床治療中取得了顯著的效果。對于血液病等疾病,該技術已成爲首選治療方法。在神經系統疾病、免疫系統疾病等領域,新基态幹細胞移植也取得了良好的治療效果。
三、治療效果保障
1.嚴格篩選适應症
爲确保治療效果,醫生在實施新基态幹細胞移植前,會對患者進行嚴格的篩選。隻有符合适應症的患者才能接受該技術治療,從而保障治療效果。
2.個性化治療方案
根據患者的具體病情,醫生會制定個性化的治療方案。在移植過程中,醫生會密切關注患者的病情變化,及時調整治療方案,确保治療效果。
3.完善的術後康複管理
新基态幹細胞移植後,患者需進行一定的康複訓練。醫院會爲患者提供完善的康複管理,包括康複評估、康複訓練、心理輔導等,以幫助患者盡快恢複生活能力。
四、結語
新基态幹細胞移植技術作爲一種新興的生物治療手段,具有廣闊的應用前景。雖然費用相對較高,但其治療效果顯著,安全性高。爲确保治療效果,患者在選擇醫院和醫生時,應關注其技術水平和臨床經驗。同時,醫院也需不斷完善術後康複管理,爲患者提供全方位的關愛。
- 2024-11-16南通免疫幹細胞價格多少錢,一針多少費用
- 2024-08-22間充質幹細胞一針多少錢,能維持多久
- 2024-10-22打幹細胞多少錢一針,打幹細胞有風險嗎
- 2024-11-06幹細胞移植骨髓增生費用詳解?
- 2024-11-11鼓樓醫院臨床幹細胞移植費用多少錢一次
- 2024-09-09脂肪幹細胞價格,國内各類幹細胞費用參考
- 2024-09-10幹細胞做幾次達到效果,做一次能保持多久
- 2024-09-02個人存儲幹細胞的費用是多少
- 2024-10-10幹細胞海河醫院治療成果如何?一文揭秘
- 2024-09-11蘋果幹細胞好處和作用有哪些附用法用量
- 2024-08-27造血幹細胞捐獻危害,對身體有影響
- 2024-09-19再生幹細胞療法是什麽,有效果嗎
- 2024-09-16糖尿病幹細胞移植能治好嗎,移植治療費用高嗎
- 2024-08-10幹細胞面部美容真的有用嗎
- 2024-10-10幹細胞療法最新臨床消息,哪些進展值得關注
- 2024-09-27韓城幹細胞存儲機構哪家信譽高?如何選擇?
- 2024-09-13蘋果幹細胞對人體的作用和功效
- 2024-08-02幹細胞療法治療,幹細胞療法可以治療哪些病
